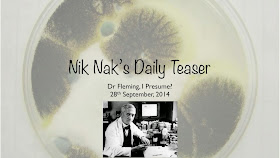

But let’s get a move on, shall we?
Q1) 28th September, 1928, saw Sir Alexander Fleming notice mould growing in his lab. What drug did he turn that mould into?
Q2) The drug in question is what: an antibiotic, an antihistamine or an anti-inflammatory?
Q3) What does the drug do: lower fever, kill bacteria or kill viruses?
Q4) The mould concerned is what: an algae, a lichen or a fungi?
Q5) Some species of the mould are use to make what: milk, cheese or biscuits?
Q6) When Sir Alexander discovered the drug, he was in his lab at Saint Mary’s Hospital. Saint Mary’s is now part of what: Imperial College London, Addenbrooks Hospital or Guys and St Thomas’?
Q7) Some of the drug’s early trials took place in which English city: Oxford, Cambridge or Brighton?
Q8) The first chemical synthesis of the drug was done by John C Sheehan: of MIT. MIT stands for ‘Massachusetts Institute of’ … what?
Q9) Sir Alexander was knighted for his work: in 1944. By which UK king … ?
Q10) Finally … In 2009, Sir Alexander was honoured by having his face on the Clydesdale Bank’s new banknotes. Which banknotes: £5, £10 or £20?
Q1) 27th September, 1777, saw the American city of Lancaster become the US capital city: for one day. Lancaster is in which US state?A1) Pennsylvania.
Q2) Which subspecies of tiger was declared extinct on 27th September, 1937: the Javan, Balinese or Sumatran?A2) The Balinese.
Q3) 27th September, 2012, saw the death — at the grand old age of 95 — of actor, Herbert Lom. In which 1955 film did he play Louis?A3) The Lady Killers.
Q4) 27th September, 1825, saw the formal opening of the Stockton and Darlington Railway: the first railway to use what kind of locomotives?A4) Steam locos.
Q5) Finally … Albert Einstein’s equation, E=mc², was published on 27th September, 1905. What did the ‘E’ stand for?A5) Energy.
“I have been trying to point out that in our lives chance may have an astonishing influence and, if I may offer advice to the young laboratory worker, it would be this - never to neglect an extraordinary appearance or happening.”
Sir Alexander Fleming, 6 August 1881 – 11 March 1955.
Looking forward to it!
ReplyDelete1. penicillin
2. antibiotic
3. kill bacteria
4. a fungi
5. cheese
6. Imperial College London
7. Oxford
8. Technology
9. King George VI
10.£5 notes